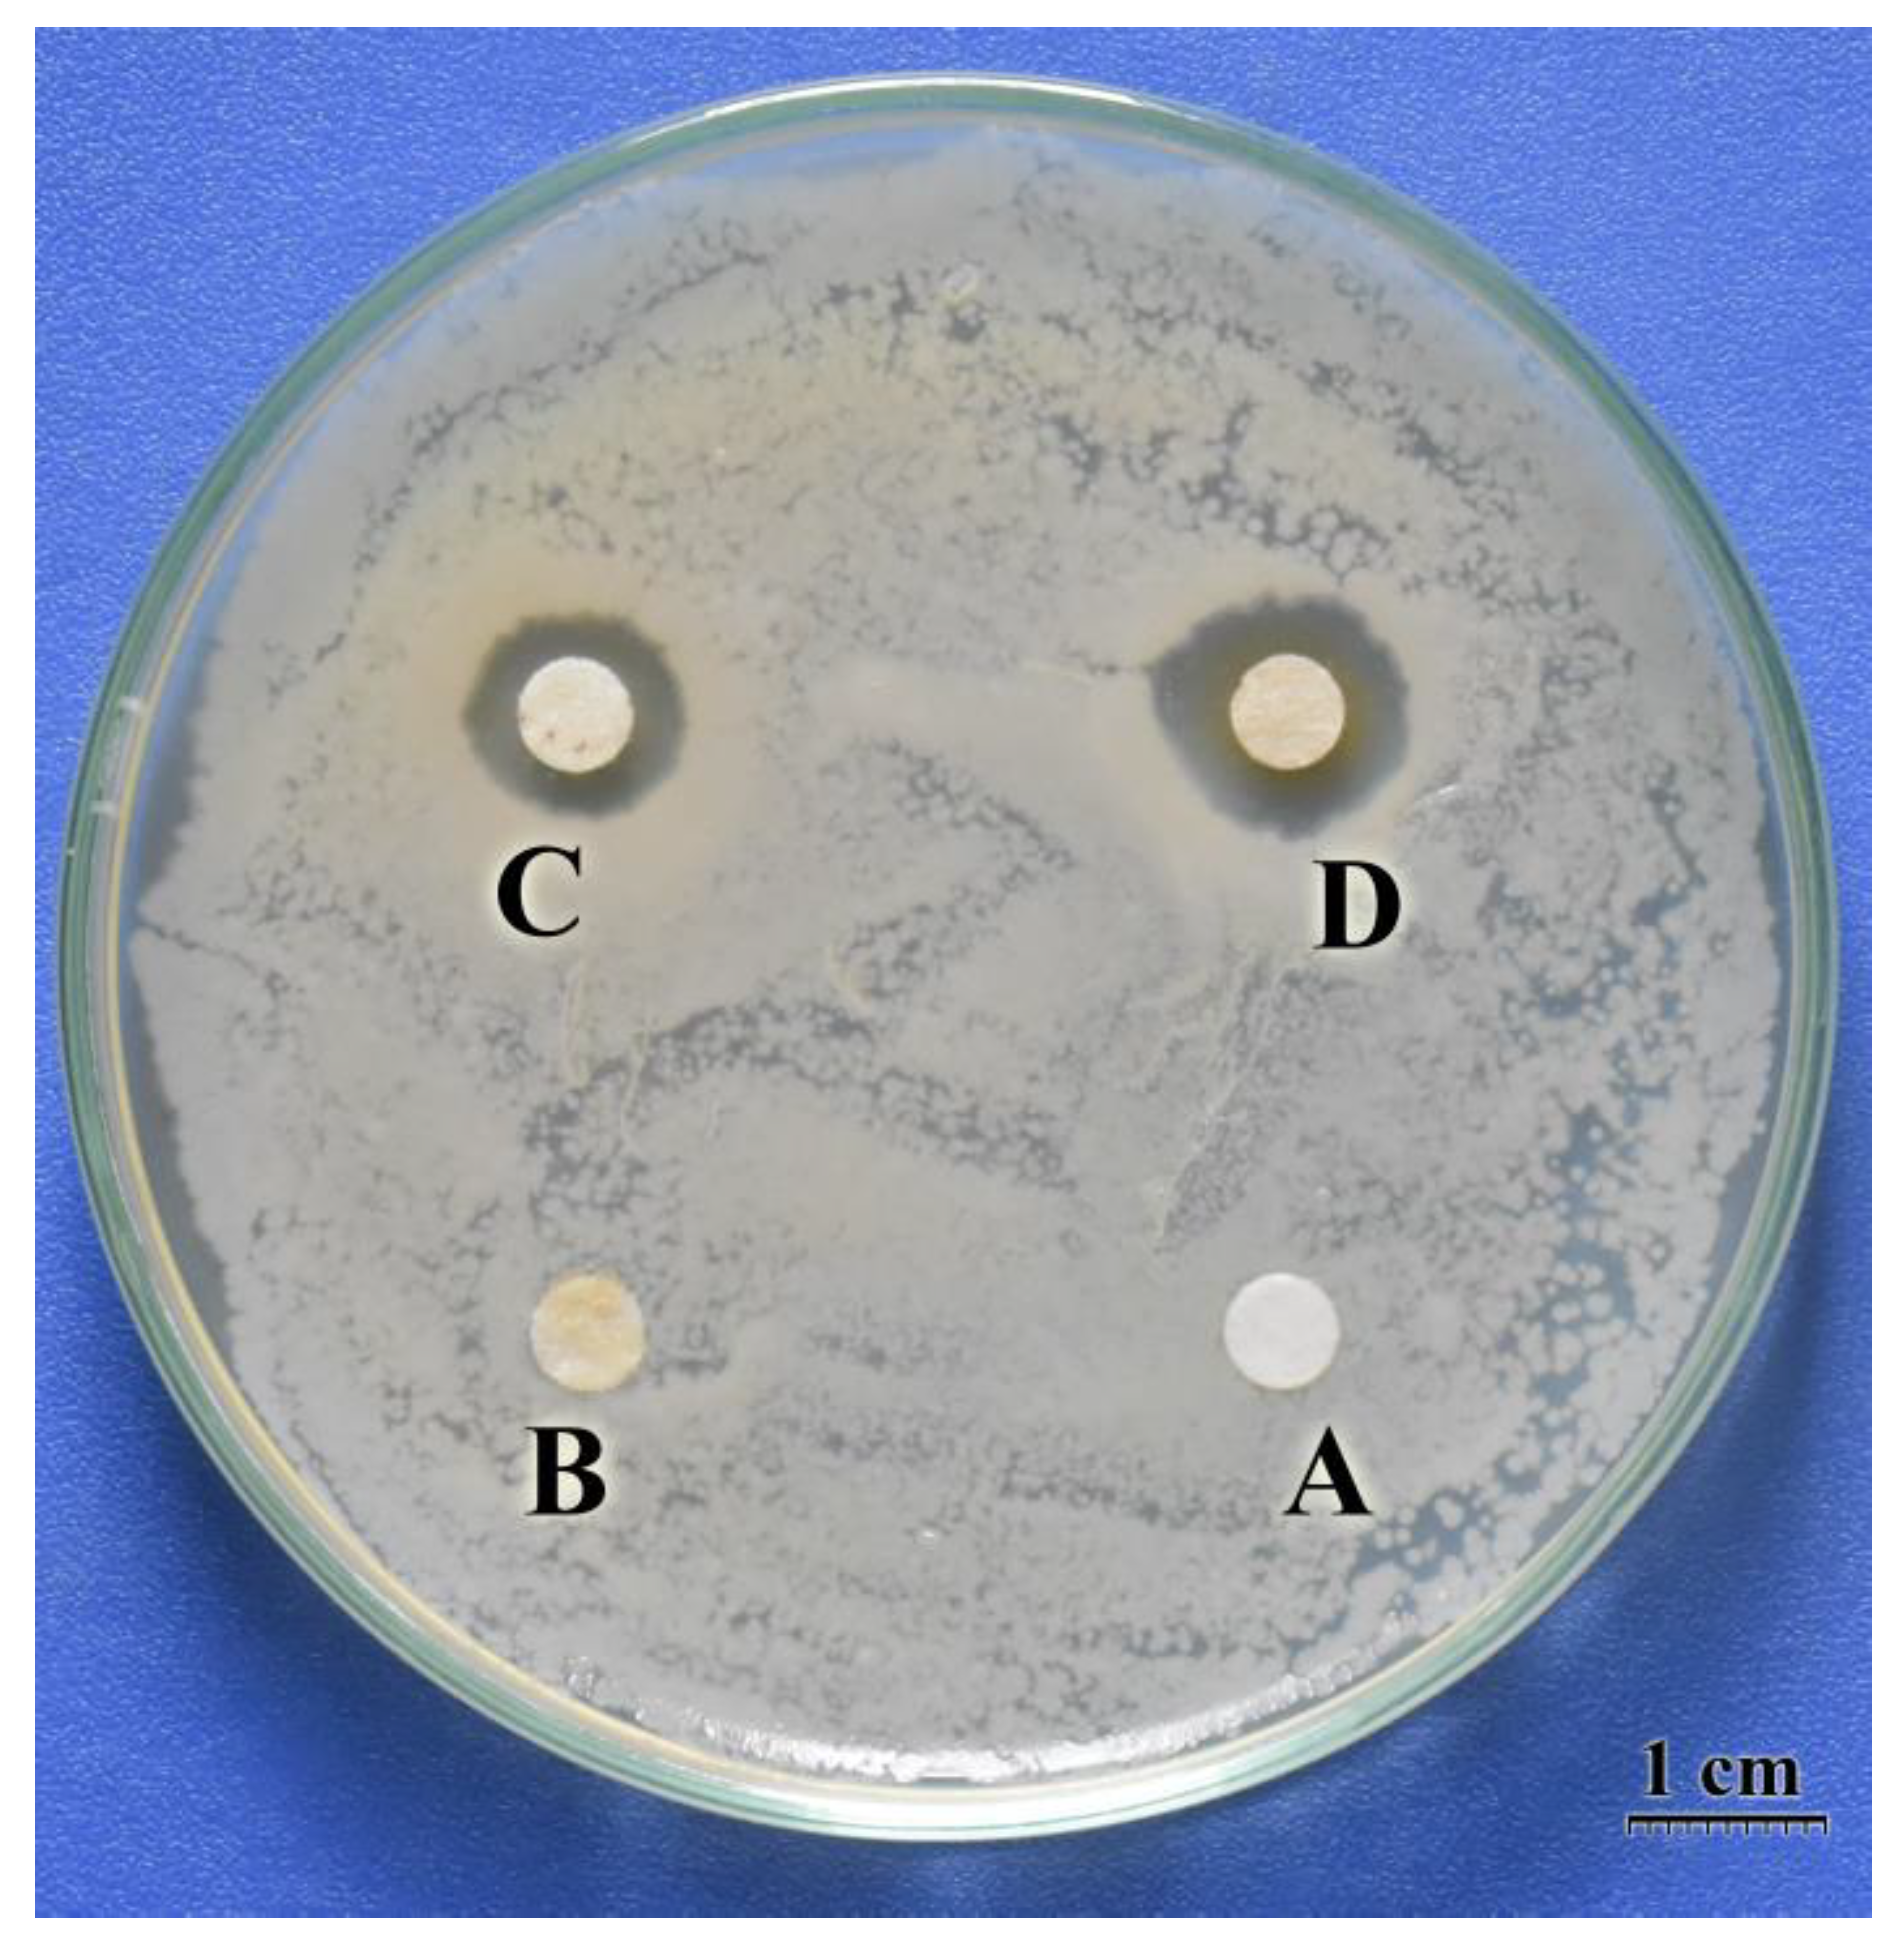
Polymers 15 04397 g006

Antibacterial Activity against Escherichia coli and Cytotoxicity of Maillard Reaction Product of Chitosan and Glucosamine Prepared by Gamma Co-60 Ray Irradiation
Abstract
:1. Introduction
2. Materials and Methods
2.1. Materials
2.2. Preparation of CTS-GA MRPs
2.3. Determination of Solubility in Water
2.4. Fourier-Transform Infrared (FTIR) Spectroscopy Analysis
2.5. Proton Nuclear Magnetic Resonance (1H-NMR) Analysis
2.6. Detection of 5-Hydroxylmethylfurfural
2.7. Evaluation of Antibacterial Activity
2.8. Evaluation of Cytotoxicity
2.9. Statistical Analysis
3. Results
3.1. Preparation of the MRPs and UV-Vis Spectrophotometric Analyses
3.2. Solubility of CTS-GA MRP Powder in Water
3.3. FTIR Spectroscopy
3.4. 1H-NMR Spectroscopy
3.5. Detection of 5-Hydroxylmethylfurfural
3.6. Antibacterial Activity
3.7. Evaluation of Cytotoxicity
4. Conclusions
Author Contributions
Funding
Institutional Review Board Statement
Data Availability Statement
Acknowledgments
Conflicts of Interest
References
- World Health Organization [WHO]. WHO Estimates of the Global Burden of Foodborne Diseases: Foodborne Disease Burden Epidemiology Reference Group 2007–2015; World Health Organization: Geneva, Switzerland, 2015; pp. 3–4. ISBN 978-92-4-156516-5. [Google Scholar]
- Gustavsson, J.; Cederberg, C.; Sonesson, U.; Van Otterdijk, R.; Meybeck, A. Global Food Losses and Food Waste—Extent, Causes and Prevention; FAO: Rome, Italy, 2011; ISBN 978-92-5-107205-9. [Google Scholar]
- Chung, Y.C.; Kuo, C.L.; Chen, C.C. Preparation and important functional properties of water-soluble chitosan produced through Maillard reaction. Bioresour. Technol. 2005, 96, 1473–1482. [Google Scholar] [CrossRef]
- Kanatt, S.R.; Chander, R.; Sharma, A. Chitosan glucose complex—A novel food preservative. Food Chem. 2008, 106, 521–528. [Google Scholar] [CrossRef]
- Dutta, P.K.; Dutta, J.; Tripathi, V.S. Chitin and chitosan: Chemistry, properties and applications. J. Sci. Ind. Res. 2004, 63, 20–31. [Google Scholar]
- Hosseinnejada, M.; Jafari, S. Evaluation of different factors affecting antimicrobial properties of chitosan. Int. J. Biol. Macromol. 2016, 85, 467–475. [Google Scholar] [CrossRef] [PubMed]
- Mahae, N.; Chalat, C.; Muhamud, P. Antioxidant and antimicrobial properties of chitosan-sugar complex. Int. Food Res. J. 2011, 18, 1543–1551. [Google Scholar]
- Ng, K.R.; Lyu, X.; Mark, R.; Chen, W.N. Antimicrobial and antioxidant activities of phenolic metabolites from flavonoid-producing yeast: Potential as natural food preservatives. Food Chem. 2019, 270, 123–129. [Google Scholar] [CrossRef]
- Tsai, G.J.; Su, W.H.; Chen, H.C.; Pan, C.L. Antimicrobial activity of shrimp chitin and chitosan from different treatments and applications of fish preservation. Fish. Sci. 2002, 68, 170–177. [Google Scholar] [CrossRef]
- Darmadji, P.; Izumimoto, M. Effect of chitosan in meat preservation. Meat Sci. 1994, 38, 243–254. [Google Scholar] [CrossRef]
- Hafsa, J.; Smach, M.A.; Mrid, R.B.; Sobeh, M.; Majdoub, H.; Yasri, A. Functional properties of chitosan derivatives obtained through Maillard reaction: A novel promising food preservative. Food Chem. 2021, 349, 129072. [Google Scholar] [CrossRef] [PubMed]
- Gullón, B.; Montenegroa, M.I.; Ruiz-Matuteb, A.I.; Cardelle-Cobasa, A.; Corzob, N.; Pintado, M.E. Synthesis, optimization and structural characterization of a chitosan-glucose derivative obtained by the Maillard reaction. Carbohydr. Polym. 2016, 137, 382–389. [Google Scholar] [CrossRef]
- Liu, S.; Sun, H.; Ma, G.; Zhang, T.; Wang, L.; Pei, H.; Li, X.; Gao, L. Insights into flavor and key influencing factors of Maillard reaction products: A recent update. Front. Nutr. 2022, 9, 973677. [Google Scholar] [CrossRef] [PubMed]
- Chung, Y.C.; Yeh, J.Y.; Tsai, C.F. Antibacterial characteristics and activity of water-soluble chitosan derivatives prepared by the Maillard reaction. Molecules 2011, 16, 8504–8514. [Google Scholar] [CrossRef]
- Chawla, S.P.; Chander, R.; Sharma, A. Antioxidant formation by γ-irradiation of glucose-amino acid model systems. Food Chem. 2007, 103, 1297–1304. [Google Scholar] [CrossRef]
- Oh, S.; Lee, Y.; Lee, J.; Kim, M.; Yook, H.; Byun, M. The effect of γ-irradiation on the non-enzymatic browning reaction in the aqueous model solutions. Food Chem. 2005, 92, 357–363. [Google Scholar] [CrossRef]
- Rao, M.S.; Chawla, S.P.; Chander, R.; Sharma, A. Antioxidant potential of Maillard reaction products formed by irradiation of chitosan-glucose solution. Carbohydr. Polym. 2011, 83, 714–719. [Google Scholar] [CrossRef]
- Quoc, L.A.; Phu, D.V.; Duy, N.N.; Thuan, N.C.; Khanh, C.N.; Hien, N.Q.; Nghiep, D.N. Study on the minimum bactericidal concentration (MBC) of Maillard reaction products of chitosan and glucosamine prepared by gamma-irradiation method. Nucl. Sci. Technol. 2021, 11, 44–51. [Google Scholar]
- Chawla, S.P.; Chander, R.; Sharma, A. Antioxidant properties of Maillard reaction products by gamma-irradiation of whey protein. Food Chem. 2009, 116, 122–128. [Google Scholar] [CrossRef]
- Theobald, A.; Müller, A.; Anklam, E. Determination of 5-hydroxymethylfurfural in vinegar samples by HPLC. J. Agric. Food Chem. 1998, 46, 1850–1854. [Google Scholar] [CrossRef]
- Balouiri, M.; Sadiki, M.; Ibnsouda, S.K. Methods for in vitro evaluating antimicrobial activity: A review. J. Pharm. Anal. 2016, 6, 71–79. [Google Scholar] [CrossRef]
- Zhang, H.; Zhang, Y.; Bao, E.; Zhao, Y. Preparation, characterization and toxicology properties of α- and β-chitosan Maillard reaction products nanoparticles. Int. J. Biol. Macromol. 2016, 89, 287–296. [Google Scholar] [CrossRef]
- Braber, N.L.V.; Vergaraa, L.I.D.; Vieyrab, F.E.M.; Borsarellib, C.D.; Yossenc, M.M.; Vegac, J.V.; Corread, S.G.; Montenegroa, M.A. Physicochemical characterization of water-soluble chitosan derivatives with singlet oxygen quenching and antibacterial capabilities. Int. J. Biol. Macromol. 2017, 102, 200–207. [Google Scholar] [CrossRef]
- Tran, T.N.; Doan, C.T.; Nguyen, V.B.; Nguyen, A.D.; Wang, S.L. Anti-oxidant and anti-diabetes potential of water-soluble chitosan-glucose derivatives produced by Maillard reaction. Polymers 2019, 11, 1714. [Google Scholar] [CrossRef]
- Kraskouski, A.; Hileuskaya, K.; Nikalaichuk, V.; Ladutska, A.; Kabanava, V.; Yao, W.; You, L. Chitosan-based Maillard self-reaction products: Formation, characterization, antioxidant and antimicrobial potential. Carbohydr. Polym. Technol. Appl. 2022, 4, 100257. [Google Scholar] [CrossRef]
- Badano, J.A.; Braber, N.V.; Rossi, Y.; Vergara, L.D.; Bohl, L.; Porporatto, C.; Falcone, R.D.; Montenegro, M. Physicochemical, in vitro antioxidant and cytotoxic properties of water-soluble chitosan-lactose derivatives. Carbohydr. Polym. 2019, 224, 115158. [Google Scholar] [CrossRef] [PubMed]
- Ferrer, E.; Algría, A.; Farré, R.; Abellán, P.; Romero, F. High-performance liquid chromatographic determination of furfural compounds in infant formulas: Changes during heat treatment and storage. J. Chromatogr. A 2002, 947, 85–95. [Google Scholar] [CrossRef] [PubMed]
- Ulbritch, R.J.; Northup, S.J.; Thomas, J.A. A review of 5-hydroxymethyl furfural (HMF) in parenteral solutions. Fundam. Appl. Toxicol. 1984, 4, 843–853. [Google Scholar] [CrossRef] [PubMed]
- Abdillahi, H.S.; Verschaeve, L.; Finnie, J.F.; Van Staden, J. Mutagenicity, antimutagenicity and cytotoxicity evaluation of South African Podocarpus species. J. Ethnopharmacol. 2012, 139, 728–738. [Google Scholar] [CrossRef] [PubMed]

| Absorbance at 284 nm | Absorbance at 420 nm | Reaction Efficiency (%) | |
|---|---|---|---|
| Before irradiation | 0.5540 ± 0.0353 a | 0.0868 ± 0.0088 a | - |
| After irradiation | 2.9612 ± 0.0278 b | 0.3695 ± 0.0314 b | 79.28 ± 1.79 |
| Sample | Cell Viability (RGR %) |
|---|---|
| Negative control | 100 ± 3.61 a |
| Positive control | 31.36 ± 4.55 b |
| MRP CTS-GA 0.1 mg/mL | 91.29 ± 4.58 c |
| MRP CTS-GA 0.25 mg/mL | 92.86 ± 3.02 c |
| MRP CTS-GA 0.5 mg/mL | 94.32 ± 2.69 c |
| MRP CTS-GA 1.0 mg/mL | 96.36 ± 2.76 c |
Disclaimer/Publisher’s Note: The statements, opinions and data contained in all publications are solely those of the individual author(s) and contributor(s) and not of MDPI and/or the editor(s). MDPI and/or the editor(s) disclaim responsibility for any injury to people or property resulting from any ideas, methods, instructions or products referred to in the content. |
© 2023 by the authors. Licensee MDPI, Basel, Switzerland. This article is an open access article distributed under the terms and conditions of the Creative Commons Attribution (CC BY) license (https://creativecommons.org/licenses/by/4.0/).
Share and Cite
Le, A.Q.; Dang, V.P.; Nguyen, N.D.; Nguyen, C.T.; Nguyen, Q.H. Antibacterial Activity against Escherichia coli and Cytotoxicity of Maillard Reaction Product of Chitosan and Glucosamine Prepared by Gamma Co-60 Ray Irradiation. Polymers 2023, 15, 4397. https://doi.org/10.3390/polym15224397
Le AQ, Dang VP, Nguyen ND, Nguyen CT, Nguyen QH. Antibacterial Activity against Escherichia coli and Cytotoxicity of Maillard Reaction Product of Chitosan and Glucosamine Prepared by Gamma Co-60 Ray Irradiation. Polymers. 2023; 15(22):4397. https://doi.org/10.3390/polym15224397
Chicago/Turabian StyleLe, Anh Quoc, Van Phu Dang, Ngoc Duy Nguyen, Chi Thuan Nguyen, and Quoc Hien Nguyen. 2023. "Antibacterial Activity against Escherichia coli and Cytotoxicity of Maillard Reaction Product of Chitosan and Glucosamine Prepared by Gamma Co-60 Ray Irradiation" Polymers 15, no. 22: 4397. https://doi.org/10.3390/polym15224397
APA StyleLe, A. Q., Dang, V. P., Nguyen, N. D., Nguyen, C. T., & Nguyen, Q. H. (2023). Antibacterial Activity against Escherichia coli and Cytotoxicity of Maillard Reaction Product of Chitosan and Glucosamine Prepared by Gamma Co-60 Ray Irradiation. Polymers, 15(22), 4397. https://doi.org/10.3390/polym15224397
